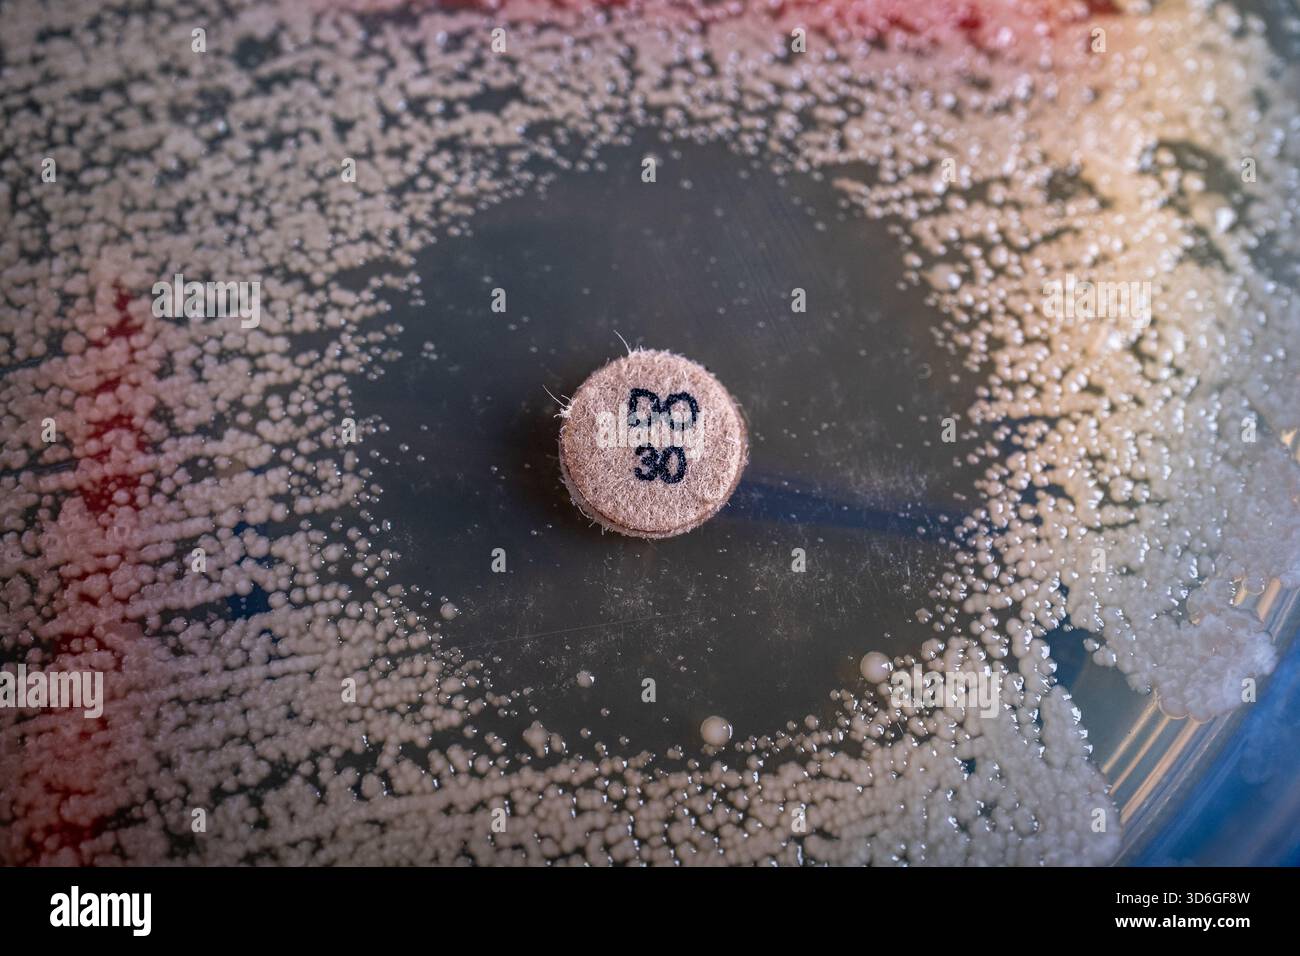
antibiotic disc diffusion on agar Stock Photo

Quick filters:
Diffusion Stock Photos and Images

RF2SAMFA0ŌĆōDramatic light rays casting vibrant rainbow colors in a tranquil atmosphere. The diffusion creates an ethereal effect, inviting peaceful reflection.

RM2DGB984ŌĆōCompagnia di Landolfo. Cultural group whose objective is the diffusion of Italian historical culture through the most prominent characters. Turin, Pie

RM2PJ9512ŌĆōStable Diffusion AI website on computer screen, an artificial intelligence program to generate images from language text descriptions

RF3DCKAKFŌĆōhigh-rise building illuminated at night, showcasing urban energy consumption and electricity usage in a modern city. The soft diffusion of electric li

RF2CC14ENŌĆōTurkey, province of Izmir, Antique Greek city of Ephesus (Roman port, important role in the diffusion of Christianity with the councils of 431 and 449

RMJ681AXŌĆōAn air pollution diffusion tube attached to a roadside pole as part of a local residents' air quality survey in Islington, North London, UK

RF2A4BN59ŌĆōSplash and crash plates of a drum, both bright and golden, hammered and with grooves for sound diffusion

RFT1WET8ŌĆōUnderside of grape leaf showing process of guttation. Guttation occurs when diffusion pressure builds inside plant because of high soil moisture and a

RM2ACC76GŌĆōTwo-dimensional waves of chemical change in a shallow dish containing Belousov-Zhabotinsky reagent. The waves radiate from point sources at a uniform

RM2JKFTPDŌĆōThis spread spectrum imaging scan, which samples 257 directions over a range of different gradient strengths, shows tractography at a triple crossover in the white matter of the parietal lobe.

RF2PHE5EBŌĆōPerson holding smartphone with website and logo of deep learning model Stable Diffusion on screen. Focus on center of phone display.

RMB2JGH7ŌĆōDiffusion tube used for the long term monitoring of air quality and pollution placed on a lamp post

RFA69X8TŌĆōWashington Monument of Baltimore Maryland magnolia flowers bloom diffusion filter Mount Vernon Place

RM2YN5110ŌĆōGaleries Laietanes, Founded in 1915 by the art dealer Santiago Segura, this was one of the centres for the diffusion of Noucentisme, not only thanks t

RF2KF11ETŌĆōBlurry Christmas lights on the Christmas tree. Pine tree decorated with shining garland.

RF2HA58C0ŌĆōDots and lines projecting from a man's tablet - networking and diffusion of innovation concept

RM2W9D1PPŌĆōraining in sunlight on landscape of old and wide lava field and inactive old volcanoes in Etna Park, Sicily, Italy (2)

RMMADREFŌĆōDiffusion Cultural Center of I.P.B.A. Ra├║l Gamboa and Iglesia de San Jose, San Luis Potosi, Mexico

RF2PHE2T8ŌĆōStable Diffusion model artificial intelligence logo on the screen of mobile phone and neural network on the screen of laptop on the background, March 2023, Prague, Czech Republic.

RF2X6625EŌĆōBlack ink swirls forming delicate patterns as they diffuse elegantly through clear water, resembling an abstract ballet.

RF3DKHYFDŌĆōSuspended Beige Ink Creates Flowing Sculptures, Dark Contrasting Background Highlights Textured Ink Art

RF2YN8B1TŌĆōSpreading paint. Purple smoky dye. Violet contrast jet diffusion of metamorphosis colors. Wavy pouring glisten leak expansion with shade darkening.

RM2DGB959ŌĆōCompagnia di Landolfo. Cultural group whose objective is the diffusion of Italian historical culture through the most prominent characters. Turin, Pie

RF2CC14E4ŌĆōTurkey, province of Izmir, Antique Greek city of Ephesus (Roman port, important role in the diffusion of Christianity with the councils of 431 and 449

RM2ACC764ŌĆōTwo-dimensional waves of chemical change in a shallow dish containing Belousov-Zhabotinsky reagent. The waves radiate from point sources at a uniform

RM2SA12AWŌĆōThis High Angular Resolution Diffusion Image (HARDI) of the human brain shows long distance connections, or tracts.

RF2PHE5F8ŌĆōMobile phone with website and logo of deep learning model Stable Diffusion on screen in front of monitor. Focus on top-left of phone display.

RM2YN50YKŌĆōGaleries Laietanes, Founded in 1915 by the art dealer Santiago Segura, this was one of the centres for the diffusion of Noucentisme, not only thanks t

RFRKF2F2ŌĆōYellow Bokeh balls abstract texture on green background. Colourful. De focused background. Blurred bright light. Circular points.

RM2W9D1PRŌĆōraining in sunlight on landscape of old and wide lava field and inactive old volcanoes in Etna Park, Sicily, Italy